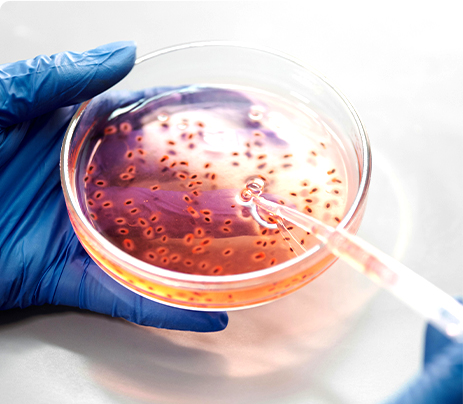
营养保健食品功效与安全性评价

业务咨询
哺乳动物实验平台
哺乳动物实验平台
Platform Introduction
平台介绍
服务领域:专注于药物与保健品的开发、临床前及临床研究。
核心服务:提供定制化动物模型、生理疾病造模、功效安全性评价及行为学分析。
技术支撑:具备深厚的技术经验与专业知识,为研发提供坚实保障。
Mammalian Efficacy Model
哺乳动物功效模型(小鼠、大鼠、猴、猫、猪、犬、兔)
相较于体外或低等动物模型,哺乳动物功效模型能在完整的活体系统中评估功效,
其结果对于人体应用具有至关重要的指导意义。
Mammalian Efficacy Model
哺乳动物疾病模型(小鼠、大鼠、猴、猫、猪、犬、兔)
全面性、高深度、专业化的哺乳动物药效评价模型
Services Offered
服务内容
药物功效与安全性评价 DRUG EFFICACY AND SAFETY EVALUATION
一项全面评估,旨在确定候选药物的治疗潜力和安全性特征。
该评价利用科学严谨的模型并遵循法规指导进行研究,为临床开发提供支持。





营养保健食品功效与安全性评价 EFFICACY OF NUTRITIONAL AND HEALTH FOODS
一项科学评估,旨在验证营养保健食品所宣称的健康功效并确保其安全性。
该评价通过严格的测试,为产品声称和法规合规提供支持。




科研服务 SCIENTIFIC RESEARCH SERVICES
一项科学评估,旨在验证营养保健食品所宣称的健康功效并确保其安全性。
该评价通过严格的测试,为产品声称和法规合规提供支持。


Application Scenarios
应用场景
Service Consultation
服务咨询
更多模型及详情,请咨询客服或拨电话咨询:139 6801 4292(微信同号)